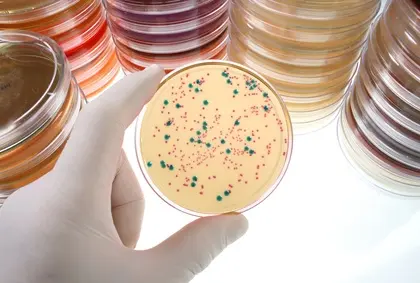
anses

Qualité

Lantech a mis au point un système unique permettant de remplir automatiquement le magasin de la formeuse de caisses. Les flans sont prélevés et placés dans le magasin quelle que soit leur configuration. Les sangles sont retirées. Aucune exigence particulière n’est requise en matière de palettes et aucune intervention humaine n’est nécessaire. Lantech@Interpack, hall 13, stand C47, du 7 au 13 mai.